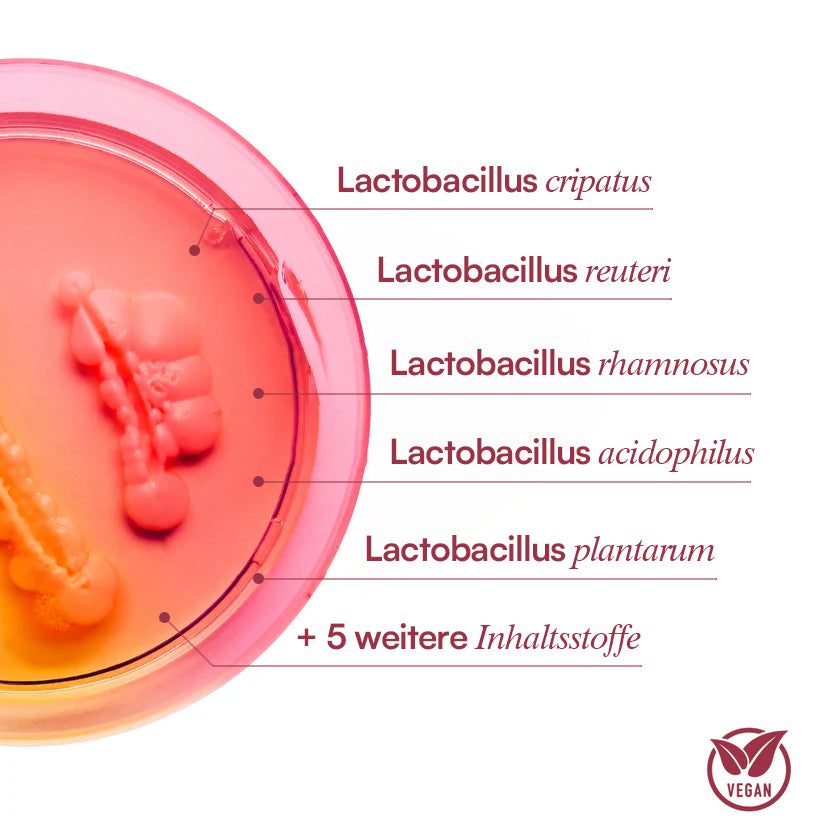

-

Vegan
-

Frei von Gentechnik
-

Hormonfrei
-

Versand aus Europa
-

Von Experten entwickelt
-

Klinisch getestet
Die Wissenschaft hinter dem Vaginal Health Complex+

Die Biologie
Die Vagina hat ein natürlich vielfältiges Mikrobiom. Wenn jedoch nicht genug Laktobazillen vorhanden sind, kann der vaginale pH-Wert zu basisch werden. Dies kann das Wachstum schädlicher Bakterien fördern und zu Beschwerden oder unangenehmen Gerüchen führen.

Wie der Vaginal Health Complex hilft
Der Vaginal Health Complex enthält 5 klinisch geprüfte Lactobacillus-Stämme sowie gezielte Präbiotika, die die guten Bakterien in deiner Vaginalflora nähren. Diese hocheffektive Kombination hilft, schädliche Keime zu verdrängen, das pH-Gleichgewicht zu stabilisieren und vaginalen Komfort sowie einen frischen, gesunden Geruch zu unterstützen.

Verifizierter Kunde
Angela O.
„Ich hatte in den letzten 3 Jahren Probleme mit Symptomen wie Intim-Geruch, Juckreiz und Ausfluss, aber innerhalb nur vier Wochen hat mir die Formel eine spürbare Linderung verschafft. Empfehlung an alle Frauen, die auch mit Symptomen untenrum zu kämpfen haben.“
100.000+ Frauen lieben
Vaginal Health Complex!
Selbst Experten empfehlen es ihren Patientinnen.

Verifizierter Kunde
Eva P.
„Komischer Geruch & Trockenheit – das waren die Symptome, die ich vor den Kapseln hatte. Seitdem ich den Health Complex einnehme, kann ich mich endlich wieder in meinen eigenen Körper, frisch und wohlfühlen.“

Verifizierter Kunde
Sarah Z.
„Seit ich die Kapseln einnehme, riecht meine Vagina wieder frisch & fühlt sich toll an. Ich muss endlich keine Gedanken mehr machen! 🙏“

Die Vorteile für Körper & Geist
Für den Körper
Vaginale pH balance
5 starke Bakterienstämme halten dein intimes Ökosystem in Harmonie. Unsere patentierte Formel hilft dabei, den vaginalen pH-Wert zu regulieren, das Risiko von Irritationen zu verringern und ein gesundes Umfeld zu schaffen, in dem nützliche Bakterien gedeihen können.
Reduzierung vaginalen Geruchs
Wenn der natürliche pH-Wert der Vagina zu basisch wird, kann dies zu mehr schädlichen, geruchsverursachenden Bakterien führen. Unsere Stämme sorgen für eine gute Ausgewogenheit & Balance.
Unterstützung der Vaginalen Flora & Vorbeugung von Infektionen
Unsere Bakterienstämme helfen bei einer gesunden vaginalen Flora und beugen somit Pilzinfektionen und Ungleichgewicht vor.
Für den Geist
Booste dein Selbstbewusstein
Fühle dich selbstbewusst und selbstsicher in deiner Haut!
Durch die Linderung von Beschwerden und die Förderung der vaginalen Gesundheit trägt unser Komplex dazu bei, dein Selbstwertgefühl zu stärken, so dass du Intimität und Beziehungen mit mehr Selbstvertrauen und Selbstbewusstsein angehen kannst.
Stärkung von intimen Beziehungen
Eine gesunde & ausgewogene Darmflora kann unangenehme Gerüche vorbeugen.
12 Inhaltsstoffe, die deiner Vagina gut tun. Von 350+ Studien belegt
Klicke einfach auf den jeweiligen Inhaltsstoff um mehr über Wirkung, Studien und Anwendung zu erfahren
-

3-fach-Schutzkapsel-Technologie™
Schützt vor Magensäure, Hitze und Feuchtigkeit, um die Kulturen sicher an ihren Zielort zu bringen
-

Lactobacillus crispatus
Unterstützt die Ansiedlung „guter“ Bakterien und das Mikrobiom-Gleichgewicht
-

Lactobacillus rhamnosus
Reduziert Ausfluss und unangenehmen Geruch für ein gesundes Intimmilieu
-

Lactobacillus acidophilus
Stabilisiert den pH-Wert und schützt vor dem Wachstum unerwünschter Bakterien
-

Lactobacillus plantarum
Fördert eine ausgeglichene pH-Balance und unterstützt die Vaginalflora
-

Mikroverkapselte Milchsäure
Reguliert den pH-Wert und schafft ein gesundes Milieu für gute Bakterien.
-

Zwei Kapseln einmal täglich
-

Zu jeder Tageszeit
-

Nach einer Mahlzeit
-

Kein Grund zur Kühlung
Erfahre was Experten über uns sagen
Bei Purefemm verwenden wir sorgfältig ausgewählte Inhaltsstoffe, die wissenschaftlich fundiert sind und höchste Reinheit und Wirksamkeit bieten.
Häufig gestellte Fragen
01 Wie wird Vaginal Health Complex eingenommen?
Nimm einfach 2 Kapseln täglich, nach einer Mahlzeit, ein.
Du kannst die Kapsel zu jeder Tageszeit einnehmen, wie es dir am besten passt.
02 Enthält es Hormone?
Nein, es handelt hierbei um ein Probiotikum mit 5 verschiedenen Bakterienstämmen und ohne jeglichen Hormonen.
03 Wie lange dauert es, bis ich eine Veränderung spüre?
Die meisten unserer Kunden berichten von spürbaren Verbesserungen nach ca. 2-3 Monaten.
Um Resultate zu spüren, ist eine kontinuierliche Einnahme ohne längere Unterbrechungen sehr wichtig.
04 Wie lange dauert der Versand und von wo wird versendet?
Alle Produkte werden aus unserem Lager in Polen versendet. Die Lieferzeit setzt, sind auch 2 verschiedenen Zeiten zusammen:
1) Bearbeitungszeit:
24-48 Stunden
2) Versandzeit:
Deutschland: 1-3 Werktage
Österreich: 3-5 Werktage
Schweiz: 3-5 Werktage
05 Wie lange kann ich retournieren?
Wir bieten eine risikofreie 100 Tage Geld Zurück Garantie auf alle Bestellungen an. Falls du unzufrieden bist schreib und einfach eine e-mail an info@purefemm.com und lass es uns gut machen.
06 Gibt es Nebenwirkungen?
Zum jetzigen Zeitpunkt sind uns keine Nebenwirkungen bekannt, falls du jedoch jegliche Nebenwirkungen entwickeln solltest, konsultiere einen Arzt und stoppe die Einnahme.
07 Kann ich es in der Schwangerschaft oder Stillzeit einnehmen?
Wenn du schwanger bist oder stillst, sprich bitte vor der Einnahme mit deinem Arzt.
08 Wie nehme ich die Kapseln ein? Zusammen oder getrennt?
Du kannst beide Kapseln gleichzeitig nach einer Mahlzeit einnehmen, wie es dir am besten passt.
Oder du teilst sie auf – z. B. eine morgens, eine abends. Wichtig ist nur, dass du sie täglich nimmst.
09 Kann ich die Kapsel öffnen und nur das Pulver einnehmen?
Wir empfehlen, die Kapsel im Ganzen einzunehmen. Sie schützt die Bakterien und sorgt für optimale Wirkung.
Wenn du Probleme beim Schlucken hast, sprich bitte mit deinem Arzt.
10 Ist der Vaginal Health Complex geeignet bei Histaminintoleranz?
Wenn du eine Histaminintoleranz hast, sprich vor der Einnahme mit deinem Arzt.
Wir achten zwar auf verträgliche Inhaltsstoffe, können aber keine individuelle Verträglichkeit garantieren.